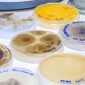

Periodista de la UFRO integra la Asociación Chilena de Periodistas y Profesionales para la Comunicación de la Ciencia (ACHIPEC)
Periodista de Bioren UFRO y conductora de Ufromedios (Efecto Ciencia) integra esta destacada red nacional de comunicadores científicos.
La periodista Natalia Bastidas, profesional del Núcleo Científico y Tecnológico en Biorecursos Bioren UFRO, fue aceptada para integrar la Asociación Chilena de Periodistas y Profesionales para la Comunicación de la Ciencia (ACHIPEC), única periodista de la UFRO en formar parte de esta red nacional.
Esta incorporación refleja no solo su compromiso con la difusión del conocimiento científico, sino también su apuesta por profesionalizar la forma en que la ciencia se comunica en y desde La Araucanía.
Formación y trayectoria
Natalia Bastidas es Licenciada en Comunicación Social, periodista (UFRO), Magíster en Gestión Estratégica de la Comunicación (UNIACC), tiene diversos diplomados entre ellos en Investigación Científica y Generación de Conocimiento en Abierto (UDD), Comunicación y Salud (UACh), formación en Ciencia Abierta por la Universidad de Antioquia. Además posee cursos de periodismo de datos, Diplomacia Científica, periodismo climático, entre otros.
En la actualidad, forma parte del equipo del Núcleo Científico y Tecnológico en Biorecursos Bioren UFRO, donde contribuye a visibilizar investigaciones científicas de alto impacto regional y nacional. Además, es conductora y productora del programa radial Efecto Ciencia, espacio radial que lleva 5 años al aire a través de Ufromedios.
Comunicar ciencia desde Temuco
“Ser parte de la ACHIPEC es una oportunidad para tejer redes, fortalecer nuestras capacidades y también poner en ese mapa a nuestra región. Hoy desde La Araucanía estamos contribuyendo a la comunicación científica y por consecuencia a la cultura científica. Sin duda hay mucho por hacer, el periodismo de ciencia necesita integrar estándares y promover buenas prácticas, ahí – por ejemplo- la ciencia abierta se presenta como una oportunidad para difundir la ciencia de forma inclusiva y descentralizada”, señala Natalia Bastidas.
Su participación en esta red nacional no solo destaca su labor como periodista, sino que también la importancia del periodismo de ciencia en la actualidad.
¿Qué es ACHIPEC?
La Asociación Chilena de Periodistas y Profesionales para la Comunicación de la Ciencia (ACHIPEC) es una organización que reúne a periodistas, divulgadores e investigadores con el fin de fortalecer el ecosistema de comunicación pública de la ciencia, la tecnología, el conocimiento y la innovación (CTCI).
Desde ACHIPEC se promueve el desarrollo de estándares éticos y profesionales para la comunicación de la ciencia. Además, de la colaboración con redes internacionales como la Red de Popularización de la Ciencia y la Tecnología en América Latina y el Caribe (RedPOP) y la World Federation of Science Journalists (WFSJ) que agrupa a periodistas y comunicadores de ciencia de todo el mundo.

Comments are closed